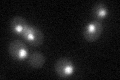
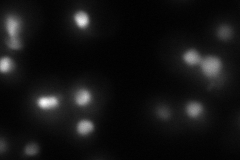
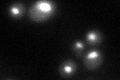

View description
Subunit of the histone deacetylase Rpd3L complex; possibly involved in cell fusion and invasive growth
Localization:
Intensity:
Fold change:
Significance:
-
C’ GFP library in SD
nucleus29.43 -
N' NOP1pr-GFP in SD

punctate,nucleus52.1312 -
N' TEF2pr-mCherry in SD
019.7099 -
N' NATIVEpr-GFP in SD

nucleus27.2377 -
N' TEF2pr-VC and Cyto-VN in SD

nucleus27.6305 -
C’ GFP library in SD+DTT
nucleus36.61.24No -
C’ GFP library in SD+H2O2

nucleus32.741.11No -
C’ GFP library in Starvation Media

nucleus28.50.96No -
C’ GFP library on the background of Pup2-DaMP

nucleus -
C’ GFP library on the background of CCT mutant

nucleus32.97751.12018No
